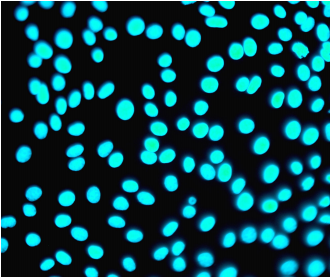
image

Introduction
服务介绍

在生物制品,特别是细胞与基因治疗领域,为满足产品快速放行,多采用核酸扩增技术(Nucleic Acid Amplification Testing, NAT)这一快速检测方法替代传统的支原体检测“金标准”(培养法)。多国药典(如USP、EP、ChP等)均提出替代方法在正式使用前,必须通过系统性验证和可比性研究,以证明其性能等同于或优于传统方法。
支原体NAT替代的核心是对两种方法(NAT法与传统培养法/指示细胞法)进行并行测试,使用涵盖常见污染菌种的标准品,评估并证明新方法在特异性、灵敏度和准确性等关键性能参数上,与传统方法具有可比性。
支原体NAT验证
目前各国药典对支原体NAT方法验证内容规定基本保持一致,主要包括特异性/专属性(Specificity)、检测限(Detection Limit,LOD)和耐用性(Robustness)验证。如使用MycoSHENTEK支原体检测试剂盒进行检测,则可采用完整试剂盒性能验证报告,再补充实际样品方法适用性验证以形成完整的方法学验证。

支原体可比性研究
可比性评估应包含NAT检测法与药典检测法的LOD对比: 以NAT法代替培养法,需证实对不同菌株的检测限达到≤10 CFU/mL;以NAT法代替指示细胞培养法,检测限必须达到≤100 CFU/mL。在这两种情况下,采用NAT法的检测和采用传统方法的检测必须同时进行,以便用相同样本(CFU可比性)对其LOD进行同步评估。
支原体检测方法要求
| 药典 | 培养法 | 指示细胞培养法 | NAT法 |
|---|---|---|---|
|
ChP <3301> |
肺炎支原体(ATCC 15531株) 口腔支原体(ATCC 23714株) |
阳性的供试品标准菌株 |
/ |
|
EP <2.6.7> |
Acholeplasma laidlawii(ATCC23206)(生产过程中使用过抗生素的人类和兽医用疫苗) Mycoplasma gallisepticum(ATCC 19610)(生产过程中使用禽类材料) Mycoplasma hyorhinis(ATCC 17981)(非禽类兽医疫苗) Mycoplasma orale(ATCC 23714)(人和兽医用疫苗) Mycoplasma pneumoniae(ATCC 15531)/Mycoplasm a fermentans(ATCC19989)(供人类使用的疫苗) Mycoplasma synoviae(ATCC25204)(在生产过程中使用过禽类材料或疫苗打算用于家禽) |
Mycoplasma hyorhinis(ATCC29052) Mycoplasma orale(ATCC 23714) |
Acholeplasma laidlawii Mycoplasma fermentans Mycoplasma orale Mycoplasma pneumoniae/Mycoplasma gallisepticum Mycoplasma synoviae(在生产过程中使用或接触过禽类材料) Mycoplasma arginini Spiroplasma citri(生产过程中使用或接触昆虫或植物物质) |
|
JP <G3-14-170> |
Mycoplasma pneumoniae(ATCC 15531,或等效菌株) Mycoplasma orale(ATCC23714,或等效菌株) |
Mycoplasma hyorhinis(ATCC 29052,ATCC17981,或等效菌株) Mycoplasma orale(ATCC23714,或等效菌株) |
Acholeplasma laidlawii(ATCC23206,或等效菌株) Mycoplasma arginini(ATCC 23838,或等效菌株) Mycoplasma fermentans(ATCC 19989或等效菌株) Mycoplasma hyorhinis(ATCC 17981,或等效菌株) Mycoplasma orale(ATCC 23714,或等效菌株) Mycoplasma pneumoniae(ATCC 15531,或等效菌株) Mycoplasma salivarium(ATCC 23064,或等效菌株) |
|
USP <77> |
Acholeplasma laidlawii(ATCC23206)(生产过程中使用过抗生素的人类和兽医用疫苗) Mycoplasma gallisepticum(ATCC 19610)(生产过程中使用禽类材料) Mycoplasma hyorhinis(ATCC 17981)(非禽类兽医疫苗) Mycoplasma orale(ATCC 23714)(人和兽医用疫苗) Mycoplasma pneumoniae(ATCC 15531)/Mycoplasm a fermentans(ATCC19989)(供人类使用的疫苗) Mycoplasma synoviae(ATCC25204)(在生产过程中使用过禽类材料或疫苗打算用于家禽) |
合适的菌株 |
Mycoplasma orale(ATCC 23714) Mycoplasma hyorhinis(ATCC 17981) Mycoplasma pneumoniae(ATCC 15531) Mycoplasma fermentans(ATCC 19989) Acholeplasma laidlawi(ATCC23206) Mycoplasma arginini(ATCC 25528) Mycoplasma synoviae(ATCC 25204) Mycoplasma gallisepticum(ATCC 19610) Spiroplasma citri(ATCC 27556) |
Advantage
服务优势
Experience
项目经验
| 序号 | 客户背景 | 委托背景 |
|---|---|---|
| 1 | 全球化Biotech/CAR-T 龙头 | 上市后变更 |
| 2 | 国内Biotech/双靶点CAR-T先锋 | 新国家/地区产品申报方法补充 |
| 3 | 创新药企,多管线CAR-T 进入临床 | BLA申报 |
| 4 | 中美两地运营的细胞治疗企业 | BLA申报 |
| 5 | 专注实体瘤TIL疗法的Biotech | BLA申报 |
| 6 | 专注自体/异体CAR-NK平台 | BLA申报 |
| 7 | 基因编辑与异体CAR-T双平台 | BLA申报 |
Contact
如您想了解更多服务方案,可通过以下联系方式找到我们。
-
张女士
-
lie_only@shenkebio.com
-
0371 - 88372661
Typical Case
典型案例
- 项目背景
- CAR-T产品,已上市产品国内BLA方法变更
- 问题核心
- 采用NAT方法(MycoSHENTEK®支原体DNA检测试剂盒)替代药典法
- 验证结果
- 经方法验证及可比性研究,NAT方法在特异性、检测限、耐用性、可比性方面均达到法规要求
- 助力申报
- 验证方案及报告获监管认可,并完成复核检,顺利完成已上市产品的方法变更
阴性对照荧光显微镜观察结果(放大倍数:x400 倍)

阳性对照(猪鼻支原体)荧光显微镜观察结果(放大倍数:x400倍)
















